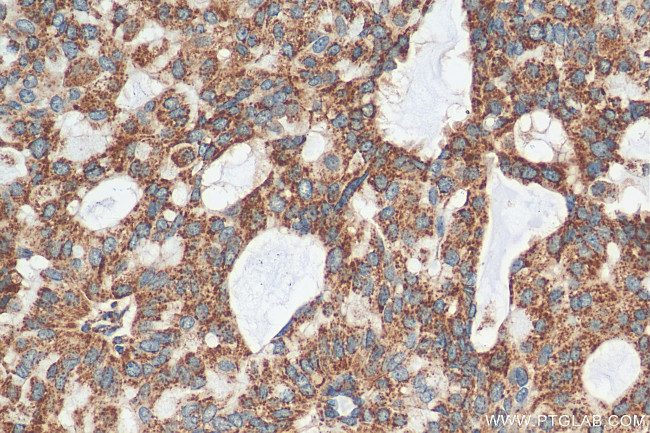
CSN2 Antibody in Immunohistochemistry (Paraffin) (IHC (P))

Search
Proteintech
CSN2 Polyclonal Antibody
{{$productOrderCtrl.translations['antibody.pdp.commerceCard.promotion.promotions']}}
{{$productOrderCtrl.translations['antibody.pdp.commerceCard.promotion.viewpromo']}}
{{$productOrderCtrl.translations['antibody.pdp.commerceCard.promotion.promocode']}}: {{promo.promoCode}} {{promo.promoTitle}} {{promo.promoDescription}}. {{$productOrderCtrl.translations['antibody.pdp.commerceCard.promotion.learnmore']}}
产品信息
30498-1-AP
种属反应
宿主/亚型
分类
类型
抗原
偶联物
形式
浓度
规格
纯化类型
保存液
内含物
保存条件
运输条件
产品详细信息
Immunogen sequence: TIESLSSSEE SITEYKQKVE KVKHEDQQQG EDEHQDKIYP SFQPQPLIYP FVEPIPYGFL PQNILPLAQP AVVLPVPQPE IMEVPKAKDT VYTKGRVMPV LKSPTIPFFD PQIPKLTDLE NLHLPLPLLQ PLMQQVPQPI PQTLALPPQP LWSVPQPKVL PIPQQVVPYP QRAVPVQALL LNQELLLNPT HQIYPVTQPL APVHNPISV
靶标信息
Isocitrate dehydrogenases catalyze the oxidative decarboxylation of isocitrate to 2-oxoglutarate. These enzymes belong to two distinct subclasses, one of which utilizes NAD(+) as the electron acceptor and the other NADP(+). Five isocitrate dehydrogenases have been reported: three NAD(+)-dependent isocitrate dehydrogenases, which localize to the mitochondrial matrix, and two NADP(+)-dependent isocitrate dehydrogenases, one of which is mitochondrial and the other predominantly cytosolic. NAD(+)-dependent isocitrate dehydrogenases catalyze the allosterically regulated rate-limiting step of the tricarboxylic acid cycle. Each isozyme is a heterotetramer that is composed of two alpha subunits, one beta subunit, and one gamma subunit. The protein encoded by this gene is the beta subunit of one isozyme of NAD(+)-dependent isocitrate dehydrogenase. Three alternatively spliced transcript variants encoding different isoforms have been described for this gene.
仅用于科研。不用于诊断过程。未经明确授权不得转售。
篇参考文献 (0)
生物信息学
蛋白别名: Alien homolog; alien-like; COP9; COP9 (constitutive photomorphogenic) homolog, subunit 2; COP9 constitutive photomorphogenic homolog subunit 2; COP9 signalosome complex subunit 2; corepressor for nuclear hormone receptors; JAB1-containing signalosome subunit 2; SGN2; signalosome subunit 2; subunit of the signalosome complex; Thyroid receptor-interacting protein 15; TR-interacting protein 15; TRIP-15; TRIP15; tyroid receptor interacting protein 15; unnamed protein product
基因别名: AI315723; ALIEN; C85265; COPS2; CSN2; SGN2; TRIP-15; TRIP15
UniProt ID: (Human) P61201, (Mouse) Q9R249, (Rat) P61203
Entrez Gene ID: (Human) 9318, (Mouse) 12848, (Rat) 261736